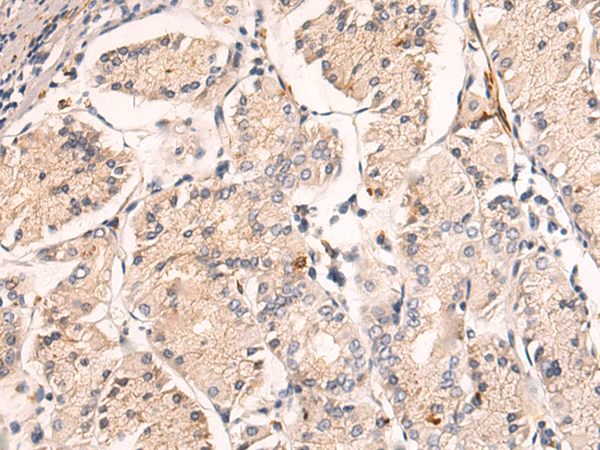

-
分类: 科研抗体货号: P03534别名:应用: WB,IHC反应种属: Human, Mouse, Rat
-
分类: 科研抗体货号: P03608别名: KIP2; USH1J; DFNB48应用: WB,IHC反应种属: Human, Mouse, Rat
-
分类: 科研抗体货号: P03528别名: ELP; SF1; FTZ1; POF7; SF-1; AD4BP; FTZF1; SPGF8; SRXX4; SRXY3; hSF-1应用: IHC反应种属: Human, Mouse, Rat
-
分类: 科研抗体货号: P03605别名: TAT; MEC17; C6orf134; Nbla00487; alpha-TAT; alpha-TAT1应用: WB反应种属: Human, Mouse, Rat
-
分类: 科研抗体货号: P03527别名: ADC; AZI2; ODCp; AZIB1; ODC-p; ODC1L应用: IHC反应种属: Human, Mouse
-
分类: 科研抗体货号: P03601别名: G7A; VARS; VARS2; NDMSCA应用: WB,IHC反应种属: Human, Mouse, Rat
-
分类: 科研抗体货号: P03515别名: H2P; SHAP应用: IHC反应种属: Human, Mouse
-
分类: 科研抗体货号: P03593别名: CAP70; CLAMP; PDZD1; NHERF3; NHERF-3应用: IHC反应种属: Human
-
分类: 科研抗体货号: P03514别名: UBR6; VIT1; FBX11; PRMT9; IDDFBA; UG063H01应用: IHC反应种属: Human, Mouse, Rat
-
分类: 科研抗体货号: P03585别名: PMLP; TM4SF11应用: WB,IHC反应种属: Human, Mouse, Rat

鄂公网安备42018502007531号
鄂公网安备42018502007531号

